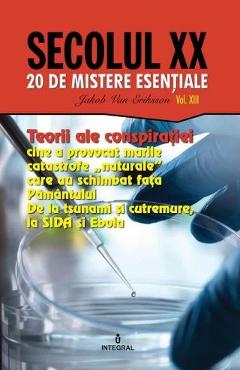

Secolul XX Vol.13: Teorii ale conspiratiei - Jakob van Eriksson

Detalii Secolul XX Vol.13: Teorii
libris.ro
20.08 Lei
21.14 Lei
Stiinte Umaniste
Jakob Van Eriksson
Secolul XX Vol.13: Teorii - Disponibil la libris.ro
Pe YEO găsești Secolul XX Vol.13: Teorii de la Jakob Van Eriksson, în categoria Stiinte Umaniste.
Indiferent de nevoile tale, Secolul XX Vol.13: Teorii ale conspiratiei - Jakob van Eriksson din categoria Stiinte Umaniste îți poate aduce un echilibru perfect între calitate și preț, cu avantaje practice și moderne.
Preț: 20.08 Lei
Caracteristicile produsului Secolul XX Vol.13: Teorii
- Brand: Jakob Van Eriksson
- Categoria: Stiinte Umaniste
- Magazin: libris.ro
- Ultima actualizare: 27-10-2025 01:24:43
Comandă Secolul XX Vol.13: Teorii Online, Simplu și Rapid
Prin intermediul platformei YEO, poți comanda Secolul XX Vol.13: Teorii de la libris.ro rapid și în siguranță. Bucură-te de o experiență de cumpărături online optimizată și descoperă cele mai bune oferte actualizate constant.
Descriere magazin:
Teorii ale conspiratiei. Cine a provocat marile catastrofe „naturale” care au schimbat fata Pamantului. De la tsunami si cutremure, la SIDA si EBOLA Este cert ca astazi exista o multime de „razboaie secrete”, care nu se duc cu mijloacele conventionale precum tancurile, mitralierele sau avioanele de lupta, ci cu metode total diferite, care presupun folosirea ultimelor cuceriri ale stiintei. Notiuni ca „razboiul geofizic”, „razboiul climatic” sau „razboiul biologic” nu mai sunt de multa vreme doar apanajul filmelor SF, ci realitati dramatice, care, adesea, scapa de sub control si pun lumea in pericol. Marile puteri, dar si industriile „strategice”, intre care nu intamplator este listata si cea farmaceutica(!), sunt aratate cu degetul pentru ravagiile pe care le produc „armele ecologice” sau „bombele bacteriologice” pe care le folosesc pe diferite meridiane sau, uneori, chiar in curtea proprie! • Cumplitul tsunami din 2004 – un test militar cu o arma ecologica? • Cutremurul din Nagorno-Karabagh si razboiul geologic – HAARP pe ruseste? • Razboiul climatic: El Nino, La Nina • Uraganul Katrina • Arma bacteriologica: SIDA, Ebola si SARS inventate in laborator?

Produse asemănătoare
Produse marca Jakob Van Eriksson
Secolul XX Vol.13: Teorii ale conspiratiei - Jakob van Eriksson
![]() libris.ro
libris.ro
Actualizat in 27/10/2025
20.08 Lei

Secolul XX Vol.5: Cum a aparut comunismul in lume - Jakob van Eriksson
![]() libris.ro
libris.ro
Actualizat in 27/10/2025
20.08 Lei

Presedintii americani. Iubirile presedintilor americani - Jakob van Eriksson
![]() libris.ro
libris.ro
Actualizat in 27/10/2025
24.53 Lei

Marile secrete ale presedintilor americani - Jakob van Eriksson
![]() libris.ro
libris.ro
Actualizat in 27/10/2025
24.53 Lei

Ciudateniile presedintilor americani - Jakob van Eriksson
![]() libris.ro
libris.ro
Actualizat in 27/10/2025
25.3 Lei

Presedintii americani... Aventurile presedintilor americani - Jakob van Eriksson
![]() libris.ro
libris.ro
Actualizat in 27/10/2025
24.53 Lei